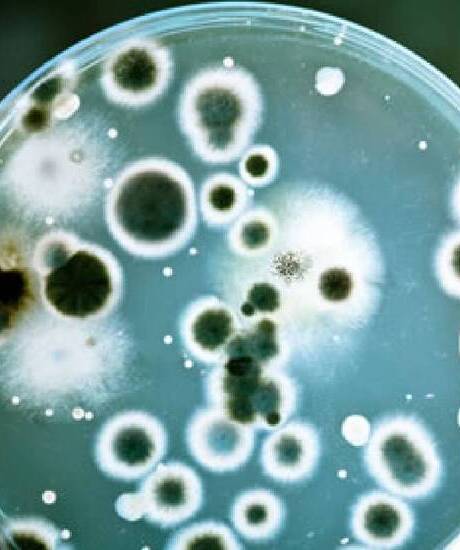

Why Medical-Grade Keyboards Are Essential for Infection Control in Hospitals
Infection control is a top priority in every healthcare facility. From operating rooms to ICUs, cleanliness can mean the difference between life and death. While healthcare professionals are vigilant about hand hygiene and surface sanitation, one often-overlooked contributor to infection risk is the humble computer keyboard. This is where medical-grade keyboards come into play.